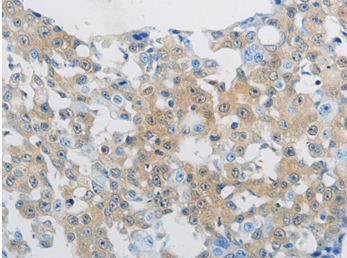

工作时间 :
周一~~周五
9:00 -18:00
在非工作时间,您可以通过邮件订购产品,订购时请写明详细联系方式,谢谢支持!
销售:18321282235
技术:021-60514606
传真:021-37680378
顾经理微信 扫一扫,关注我们
CLEC4C Polyclonal Antibody
DLEC, HECL, BDCA2, CD303, CLECSF7, CLECSF11, PRO34150
货号:YBAP16363 |
|
![]() |
|
规格: 50ul/100ul/200ul |
|
价格: 980/1280/1890 |
|
| Immunogen: | Synthetic peptide of human CLEC4C | ||
Synonym: |
DLEC, HECL, BDCA2, CD303, CLECSF7, CLECSF11, PRO34150 | ||
| Calculated MW: | |||
| Observed MW: | |||
Source: |
Rabbit | ||
Isotype: |
IgG | ||
Application: |
ELISA IHC | ||
Purify: |
Affinity purification | ||
Concentration: |
2.2mg | ||
Storage Buffer: |
PBS with 0.05% sodium azide, 50% glycerol, pH7.3 | ||
Storage: |
Store at -20℃. Avoid freeze / thaw cycles. |
||
| Immunohistochemistry of Human breast cancer using CLEC4C Polyclonal Antibody at dilution of 1:70 |
Protocols: |
Buffer-Formulation WB-Guide IHC-Guide IP-Guide IF-Guide |
||
Background: |
This gene encodes a member of the C-type lectin/C-type lectin-like domain (CTL/CTLD) superfamily. Members of this family share a common protein fold and have diverse functions, such as cell adhesion, cell-cell signalling, glycoprotein turnover, and roles in inflammation and immune response. The encoded type 2 transmembrane protein may play a role in dendritic cell function. Two transcript variants encoding distinct isoforms have been identified for this gene.
|
||
部门 |
姓名 | 手机 | |||
| 销售部 | 顾先生 | 1916510334@qq.com | 18321282235 | 1916510334 | |
| 技术部 | 技术支持 | 1781364813@qq.com | 13816899465 | 1781364813 |
全国免费电话:18321282235
销售: 18321282235
86-21-60514606
技术: 13816899465
传真: 021-37680378
The latest products